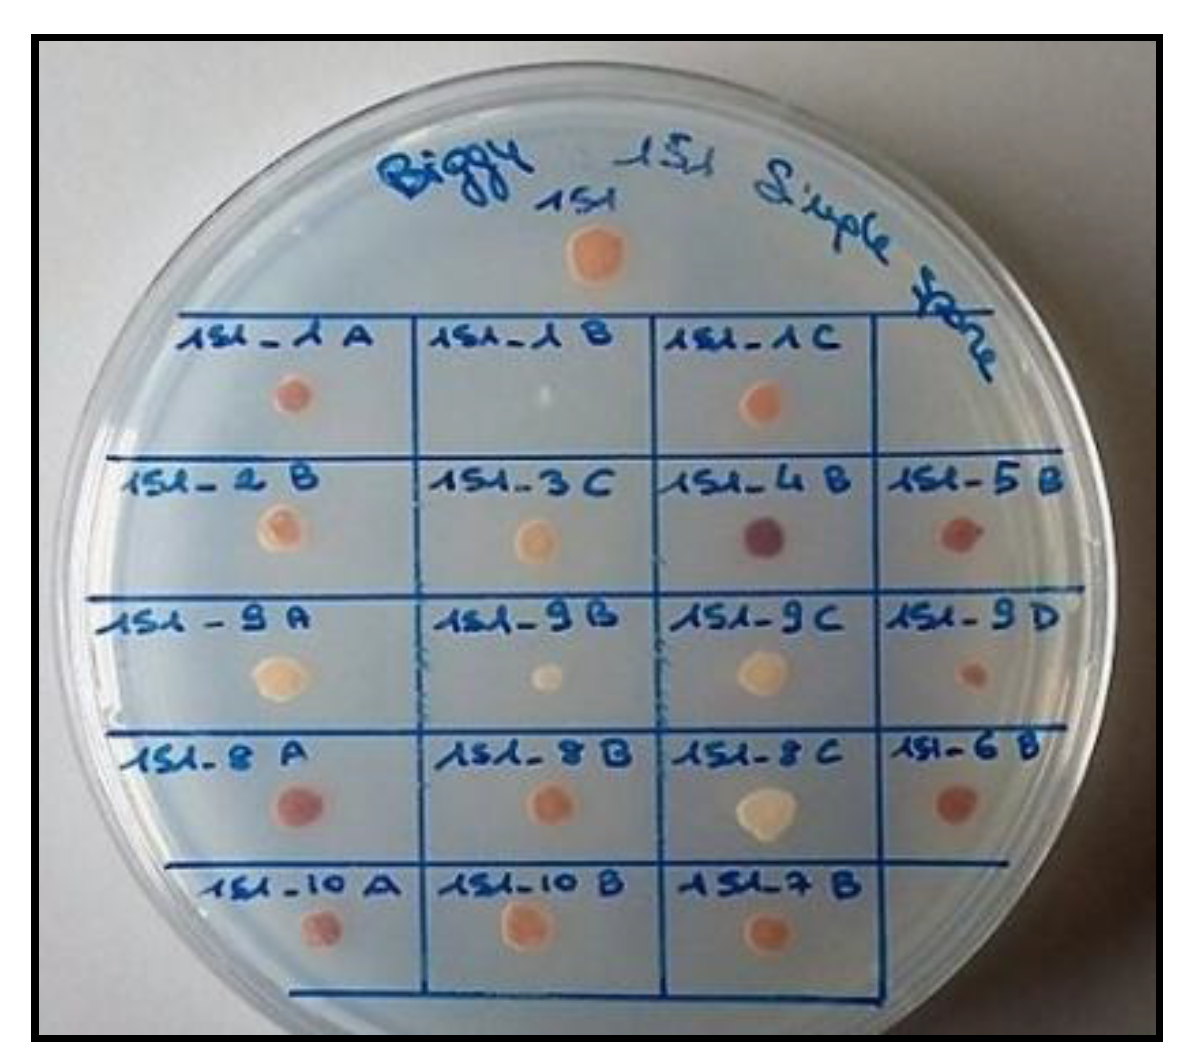
Foods 09 00658 g001 Foods 09 00658 g001

Reduction of Sulfur Compounds through Genetic Improvement of Native Saccharomyces cerevisiae Useful for Organic and Sulfite-Free Wine
Abstract
1. Introduction
2. Materials and Methods
2.1. Native S. cerevisiae Strain
2.2. Yeast’s Sporulation Procedure and Spore Analyses for H2S Production
2.3. Sexual Recombination of Spores and New Strain Selection
2.4. Molecular Fingerprinting
2.5. Genomic Stabilization
2.6. Fermentative Aptitudes: Microvinification Trials
2.6.1. Main Analytical Compounds of Wines
2.6.2. Main Byproducts of Fermentation and Volatile Compounds
2.7. Statistical Analyses
3. Results
3.1. H2S Production by the Viable Spores
3.2. Phenotypic Selection of the Improved S. cerevisiae Strains
3.3. Molecular Fingerprinting of the Potential Improved Strains
3.4. Effects of the Genomic Stabilization on Interdelta Sequences and H2S Production of the Improved Strains
3.5. Microvinification Trials
3.5.1. Fermentation Kinetics
3.5.2. Main Analytical Compounds
3.5.3. The Main Byproducts and Volatile Compounds of Fermentation
3.5.4. Principal Component Analysis (PCA)
4. Discussion
5. Conclusions
Author Contributions
Funding
Acknowledgments
Conflicts of Interest
References
- Vaughan-Martini, A.; Martini, A. Saccharomyces meyen ex reess (1870). In The Yeasts; Elsevier: Burlington, MA, USA, 2011; Volume 2, pp. 733–746. [Google Scholar]
- Piškur, J.; Rozpedowska, E.; Polakova, S.; Merico, A.; Compagno, C. How did Saccharomyces evolve to become a good brewer? Trends Genet. 2006, 22, 183–186. [Google Scholar] [CrossRef] [PubMed]
- Dashko, S.; Zhou, N.; Compagno, C.; Pitt, J.P.W.; Piškur, J. Why, when, and how did yeast evolve alcoholic fermentation? FEMS Yeast Res. 2014, 14, 826–832. [Google Scholar] [CrossRef] [PubMed]
- Vigentini, I.; Fabrizio, V.; Faccincani, M.; Picozzi, C.; Comasio, A.; Foschino, R. Dynamics of Saccharomyces cerevisiae populations in controlled and spontaneous fermentations for Franciacorta, D.O.C.G. base wine production. Ann. Microbiol. 2014, 64, 639–651. [Google Scholar] [CrossRef]
- Guillamón, J.M.; Barrio, E. Genetic polymorphism in wine yeasts: Mechanisms and methods for its detection. Front. Microbiol. 2017, 8, 806. [Google Scholar] [CrossRef] [PubMed]
- Romano, P.; Caruso, M.; Capece, A.; Lipani, G.; Paraggio, M.; Fiore, C. Metabolic diversity of Saccharomyces cerevisiae strains from spontaneously fermented grape musts. World J. Microl. Biot. 2003, 19, 311–315. [Google Scholar] [CrossRef]
- Aa, E.; Townsend, J.P.; Adams, R.I.; Nielsen, K.M.; Taylor, J.W. Population structure and gene evolution in Saccharomyces cerevisiae. FEMS Yeast Res. 2006, 6, 702–715. [Google Scholar] [CrossRef]
- Callejon, R.M.; Clavijo, A.; Ortigueira, P.; Troncoso, A.M.; Paneque, P.; Morales, M.L. Volatile and sensory profile of organic red wines produced by different selected autochthonous and commercial Saccharomyces cerevisiae strains. Anal. Chim. Acta 2010, 660, 68–75. [Google Scholar] [CrossRef]
- Orlić, S.; Vojvoda, T.; Babić, K.H.; Arroyo-López, F.N.; Jeromel, A.; Kozina, B.; Comi, G. Diversity and oenological characterization of indigenous Saccharomyces cerevisiae associated with Žilavka grapes. World J. Microl. Biot. 2010, 26, 1483–1489. [Google Scholar] [CrossRef]
- Camarasa, C.; Sanchez, I.; Brial, P.; Bigey, F.; Dequin, S. Phenotypic landscape of Saccharomyces cerevisiae during wine fermentation: Evidence for origin-dependent metabolic traits. PLoS ONE 2011, 6, e25147. [Google Scholar] [CrossRef]
- Capozzi, V.; Garofalo, C.; Chiriatti, M.A.; Grieco, F.; Spano, G. Microbial terroir and food innovation: The case of yeast biodiversity in wine. Microbiol. Res. 2015, 181, 75–83. [Google Scholar] [CrossRef]
- Liti, G.; Carter, D.M.; Moses, A.M.; Warringer, J.; Parts, L.; James, S.A.; Davey, R.P.; Roberts, I.N.; Burt, A.; Koufopanou, V.; et al. Population genomics of domestic and wild yeasts. Nature 2009, 458, 337–341. [Google Scholar] [CrossRef] [PubMed]
- Mercado, L.; Sturm, M.E.; Rojo, M.C.; Ciklic, I.; Martínez, C.; Combina, M. Biodiversity of Saccharomyces cerevisiae populations in Malbec vineyards from the “Zona Alta del Río Mendoza” region in Argentina. Int. J. Food Microbiol. 2011, 151, 319–326. [Google Scholar] [CrossRef] [PubMed]
- Scacco, A.; Oliva, D.; Di Maio, S.; Polizzotto, G.; Genna, G.; Tripodi, G.; Lanza, C.M.; Verzera, A. Indigenous Saccharomyces cerevisiae strains and their influence on the quality of Cataratto, Inzolia and Grillo white wines. Food Res. Int. 2012, 46, 1–9. [Google Scholar] [CrossRef]
- Capece, A.; Siesto, G.; Romaniello, R.; Lagreca, V.M.; Pietrafesa, R.; Calabretti, A.; Romano, P. Assessment of competition in wine fermentation among wild Saccharomyces cerevisiae strains isolated from Sangiovese grapes in Tuscany region. Lebensm-Wiss. Technol. 2013, 54, 485–492. [Google Scholar] [CrossRef]
- Tofalo, R.; Perpetuini, G.; Schirone, M.; Fasoli, G.; Aguzzi, I.; Corsetti, A.; Suzzi, G. Biogeographical characterization of Saccharomyces cerevisiae wine yeast by molecular methods. Front. Microbiol. 2013, 4, 166. [Google Scholar] [CrossRef]
- Tofalo, R.; Perpetuini, G.; Fasoli, G.; Schirone, M.; Corsetti, A.; Suzzi, G. Biodiversity study of wine yeasts belonging to the “terroir” of Montepulciano d’Abruzzo “Colline Teramane” revealed Saccharomyces cerevisiae strains exhibiting atypical and unique 5.8 S-ITS restriction patterns. Food Microbiol. 2014, 39, 7–12. [Google Scholar] [CrossRef]
- Bokulich, N.A.; Collins, T.S.; Masarweh, C.; Allen, G.; Heymann, H.; Ebeler, S.E.; Mills, D.A. Associations among wine grape microbiome, metabolome, and fermentation behavior suggest microbial contribution to regional wine characteristics. mBio 2016, 7, e00631-16. [Google Scholar] [CrossRef]
- Swiegers, J.H.; Pretorius, I.S. Modulation of volatile sulfur compounds by wine yeast. Appl. Microbiol. Biotechnol. 2007, 74, 954–960. [Google Scholar] [CrossRef]
- Ugliano, M.; Fedrizzi, B.; Siebert, T.; Travis, B.; Magno, F.; Versini, G.; Henschke, P.A. Effect of nitrogen supplementation and Saccharomyces species on hydrogen sulfide and other volatile sulfur compounds in Shiraz fermentation and wine. J. Agric. Food Chem. 2009, 57, 4948–4955. [Google Scholar] [CrossRef]
- Noble, J.; Sanchez, I.; Blondin, B. Identification of new Saccharomyces cerevisiae variants of the MET2 and SKP2 genes controlling the sulfur assimilation pathway and the production of undesirable sulfur compounds during alcoholic fermentation. Microb. Cell Factories 2015, 14, 68. [Google Scholar] [CrossRef]
- De Vero, L.; Solieri, L.; Giudici, P. Evolution-based strategy to generate non-genetically modified organisms Saccharomyces cerevisiae strains impaired in sulfate assimilation pathway. Lett. Appl. Microbiol. 2011, 53, 572–575. [Google Scholar] [CrossRef] [PubMed]
- Liu, X.Z.; Zhang, Z.M.; Zhang, H.Y. Cross breeding and hybrid identification of sulphite-tolerant hybrids of Saccharomyces uvarum. S. Afr. J. Enol. Vitic. 2017, 38, 125–131. [Google Scholar] [CrossRef][Green Version]
- Linderholm, A.L.; Findleton, C.L.; Kumar, G.; Hong, Y.; Bisson, L.F. Identification of genes affecting hydrogen sulfide formation in Saccharomyces cerevisiae. Appl. Environ. Microbiol. 2008, 74, 1418–1427. [Google Scholar] [CrossRef] [PubMed]
- Carrete, R.; Vidal, M.T.; Bordons, A.; Constantí, M. Inhibitory effect of sulfur dioxide and other stress compounds in wine on the ATPase activity of Oenococcus oeni. FEMS Microbiol. Lett. 2002, 211, 155–159. [Google Scholar] [CrossRef]
- Komarnisky, L.A.; Christopherson, R.J.; Basu, T.K. Sulfur: Its clinical and toxicologic aspects. Nutrition 2003, 19, 54–61. [Google Scholar] [CrossRef]
- Mendes-Ferreira, A.; Barbosa, C.; Falco, V.; Leão, C.; Mendes-Faia, A. The production of hydrogen sulphide and other aroma compounds by wine strains of Saccharomyces cerevisiae in synthetic media with different nitrogen concentrations. J. Ind. Microbiol. Biot. 2009, 36, 571–583. [Google Scholar] [CrossRef] [PubMed]
- Cravero, M.C. Organic and biodynamic wines quality and characteristics: A review. Food Chem. 2019, 295, 334–340. [Google Scholar] [CrossRef]
- Mannazzu, I.; Simonetti, E.; Marinangeli, P.; Guerra, E.; Budroni, M.; Thangavelu, M.; Clementi, F. SED1 gene length and sequence polymorphisms in feral strains of Saccharomyces cerevisiae. Appl. Environ. Microbiol. 2002, 68, 5437–5444. [Google Scholar] [CrossRef]
- Legras, J.L.; Karst, F. Optimisation of interdelta analysis for Saccharomyces cerevisiae strain characterisation. FEMS Microbiol. Lett. 2003, 221, 249–255. [Google Scholar] [CrossRef]
- Ciani, M.; Ferraro, L. Enhanced glycerol content in wines made with immobilized Candida stellata cells. Appl. Environ. Microbiol. 1996, 62, 128–132. [Google Scholar] [CrossRef]
- Steensels, J.; Meersman, E.; Snoek, T.; Saels, V.; Verstrepen, K.J. Large-scale selection and breeding to generate industrial yeasts with superior aroma production. Appl. Environ. Microbiol. 2014, 80, 6965–6975. [Google Scholar] [CrossRef] [PubMed]
- Canonico, L.; Comitini, F.; Ciani, M. Torulaspora delbrueckii for secondary fermentation in sparkling wine production. Food Microbiol. 2018, 74, 100–106. [Google Scholar] [CrossRef] [PubMed]
- Canonico, L.; Comitini, F.; Ciani, M. Metschnikowia pulcherrima selected strain for ethanol reduction in wine: Influence of cell immobilization and aeration condition. Foods 2019, 8, 378. [Google Scholar] [CrossRef] [PubMed]
- Pretorius, I.S. Tailoring wine yeast for the new millennium: Novel approaches to the ancient art of winemaking. Yeast 2000, 16, 675–729. [Google Scholar] [CrossRef]
- Cebollero, E.; Gonzalez-Ramos, D.; Tabera, L.; Gonzalez, R. Transgenic wine yeast technology comes of age: Is it time for transgenic wine? Biotechnol. Lett. 2007, 29, 191–200. [Google Scholar] [CrossRef]
- Pérez-Través, L.; Lopes, C.A.; Barrio, E.; Querol, A. Evaluation of different genetic procedures for the generation of artificial hybrids in Saccharomyces genus for winemaking. J. Food Microbiol. 2012, 156, 102–111. [Google Scholar] [CrossRef]
- Bizaj, E.; Cordente, A.G.; Bellon, J.R.; Raspor, P.; Curtin, C.D.; Pretorius, I.S. A breeding strategy to harness flavor diversity of Saccharomyces interspecific hybrids and minimize hydrogen sulfide production. FEMS Yeast Res. 2012, 12, 456–465. [Google Scholar] [CrossRef]
- Casalta, E.; Vernhet, A.; Sablayrolles, J.M.; Tesnière, C.; Salmon, J.M. Characterization and role of grape solids during alcoholic fermentation under enological conditions. Am. J. Enol. Vitic. 2016, 67, 133–138. [Google Scholar] [CrossRef]
- Wang, X.D.; Bohlscheid, J.C.; Edwards, C.G. Fermentative activity and production of volatile compounds by Saccharomyces grown in synthetic grape juice media deficient in assimilable nitrogen and/or pantothenic acid. J. Appl. Microbiol. 2003, 94, 349–359. [Google Scholar] [CrossRef]
- Torrens, J.; Urpí, P.; Riu-Aumatell, M.; Vichi, S.; López-Tamames, E.; Buxaderas, S. Different commercial yeast strains affecting the volatile and sensory profile of cava base wine. J. Food Microbiol. 2008, 124, 48–57. [Google Scholar] [CrossRef]
- Knight, S.; Goddard, M.R. Quantifying separation and similarity in a Saccharomyces cerevisiae metapopulation. ISME J. 2015, 9, 361–370. [Google Scholar] [CrossRef] [PubMed]
- Capece, A.; Granchi, L.; Guerrini, S.; Mangani, S.; Romaniello, R.; Vincenzini, M.; Romano, P. Diversity of Saccharomyces cerevisiae strains isolated from two Italian wine-producing regions. Front. Microbiol. 2016, 7, 1018. [Google Scholar] [CrossRef] [PubMed]
- Agarbati, A.; Canonico, L.; Ciani, M.; Comitini, F. Fitness of selected indigenous Saccharomyces cerevisiae strains for white Piceno DOC wines production. Fermentation 2018, 4, 37. [Google Scholar] [CrossRef]

); DiSVA 705 (
); I1 (
); I4 (
); B4 (
). The graph represented the fermentation trend in NGJ. The results were the mean values and the standard deviations were represented as error bars.
); DiSVA 705 (
); I1 (
); I4 (
); B4 (
). The graph represented the fermentation trend in NGJ. The results were the mean values and the standard deviations were represented as error bars.

| Spores Name | H2S Production |
|---|---|
| 1_A | ++ |
| 1_B | − |
| 1_C | ++ |
| 2_B | ++ |
| 3_C | ++ |
| 4_B | +++ |
| 5_B | +++ |
| 6_B | +++ |
| 7_B | ++ |
| 8_A | +++ |
| 8_B | ++ |
| 8_C | − |
| 9_A | + |
| 9_B | − |
| 9_C | − |
| 9_D | ++ |
| 10_A | +++ |
| 10_B | ++ |
| SGJ | NGJ | |||||
|---|---|---|---|---|---|---|
| Strains | Ethanol (% v/v) | Acetic Acid (g/L) | Total SO2 (mg/L) | Ethanol (% v/v) | Acetic Acid (g/L) | Total SO2 (mg/L) |
| OKAY | 13.00 ± 0.15 ab | 0.81 ± 0.05 a | 0.29 ± 0.01 c | 13.65 ± 0.06 ab | 0.39 ± 0.02 b | 6.85 ± 0.49 e |
| DiSVA 705 | 13.14 ± 0.02 a | 0.77 ± 0.01 ab | 3.81 ± 0.43 ab | 14.04 ± 0.17 a | 0.31 ± 0.02 c | 32.29 ± 0.87 a |
| G4 | 13.17 ± 0.03 a | 0.74 ± 0.03 ab | 4.89 ± 2.06 a | 13.49 ± 0.24 b | 0.43 ± 0.01 b | 12.56 ± 0.45 d |
| I1 | 13.15 ± 0.12 a | 0.72 ± 0.09 b | 5.40 ± 1.28 a | 13.84 ± 0.26 ab | 0.53 ± 0.03 a | 22.35 ± 0.78 b |
| I4 | 12.71 ± 0.45 b | 0.73 ± 0.02 ab | 2.28 ± 1.43 bc | 12.74 ± 0.28 c | 0.49 ± 0.01 a | 17.44 ± 0.57 c |
| B4 | 13.21 ± 0.01 a | 0.75 ± 0.00 ab | 0.76 ± 0.40 c | 13.69 ± 0.48 ab | 0.50 ± 0.05 a | 32.37 ± 1.05 a |
| Main by-Products in SGJ (mg/L) | Yeast Strains | ||||
|---|---|---|---|---|---|
| Carbonyl Compounds | OKAY | DiSVA 705 | I1 | I4 | B4 |
| Acetaldehyde | 15.21 ± 0.16 b | 13.91 ± 0.05 b | 17.96 ± 1.74 a | 13.84 ± 0.13 b | 15.12 ± 1.19 b |
| Esters | |||||
| Ethyl acetate | 18.69 ± 0.64 b | 22.29 ± 0.31 a | 17.54 ± 0.26 b | 11.27 ± 2.08 d | 14.50 ± 0.28 c |
| Alcohols | |||||
| n-propanol | 41.61 ± 0.44 a | 19.24 ± 0.41 b | 20.53 ± 0.51 b | 21.99 ± 4.87 b | 19.02 ± 0.54 b |
| Isobutanol | 19.66 ± 0.27 a | 14.81 ± 0.14 b | 7.69 ± 0.85 c | 6.61 ± 0.50 d | 8.61 ± 0.32 c |
| Amyl alcohol | 18.88 ± 0.44 a | 12.24 ± 0.17 b | 8.88 ± 0.82 c | 9.08 ± 0.64 c | 8.11 ± 1.10 c |
| Isoamyl alcohol | 47.51 ± 0.11 a | 35.90 ± 0.05 b | 29.41 ± 1.22 c | 29.45 ± 2.60 c | 27.35 ± 2.95 c |
| Main by-Products in NGJ (mg/L) | Yeast Strains | ||||
|---|---|---|---|---|---|
| Carbonyl Compounds | OKAY | DiSVA 705 | I1 | I4 | B4 |
| Acetaldehyde | 12.53 ± 0.05 e | 63.46 ± 0.47 c | 89.66 ± 0.10 a | 70.52 ± 0.02 b | 57.00 ± 0.01 d |
| Esters | |||||
| Isoamyl acetate | 1.53 ± 0.21 a | 0.37 ± 0.08 c | 1.26 ± 0.15 ab | 1.27 ± 0.01 ab | 1.05 ± 0.16 b |
| Phenylethyl acetate | 0.77 ± 0.00 a | 0.14 ± 0.05 b | 0.10 ± 0.05 bc | 0.04 ± 0.01 c | 0.05 ± 0.01 c |
| Ethyl hexanoate | 0.08 ± 0.01 d | 0.34 ± 0.01 a | 0.26 ± 0.01 bc | 0.22 ± 0.00 c | 0.30 ± 0.06 ab |
| Ethyl butyrate | 0.87 ± 0.09 a | 0.03 ± 0.01 b | 0.09 ± 0.00 b | 0.07 ± 0.00 b | 0.06 ± 0.01 b |
| Ethyl acetate | 20.38 ± 0.57 b | 20.58 ± 1.38 b | 31.15 ± 0.11 a | 16.67 ± 0.89 c | 22.09 ± 0.65 b |
| Alcohols | |||||
| n-propanol | 40.56 ± 1.27 d | 20.95 ± 0.39 e | 59.30 ± 0.34 b | 69.83 ± 1.00 a | 49.36 ± 0.17 c |
| Isobutanol | 5.65 ± 0.42 c | 17.18 ± 0.53 a | 7.34 ± 0.40 b | 7.77 ± 0.76 b | 7.60 ± 0.16 b |
| Amyl alcohol | 14.60 ± 1.53 b | 19.76 ± 0.98 a | 8.70 ± 0.13 d | 12.20 ± 0.92 c | 6.85 ± 0.42 d |
| β-Phenyl ethanol | 24.93 ± 1.32 a | 16.24 ± 0.75 b | 8.54 ± 0.82 c | 6.28 ± 0.33 cd | 5.81 ± 1.07 d |
| Hexanol | 0.09 ± 0.02 a | 0.07 ± 0.00 ab | 0.05 ± 0.01 b | 0.06 ± 0.01 b | 0.07 ± 0.01 ab |
| Isoamyl alcohol | 94.21 ± 1.25 b | 115.61 ± 0.70 a | 58.03 ± 0.29 d | 56.51 ± 0.36 d | 62.35 ± 0.36 c |
© 2020 by the authors. Licensee MDPI, Basel, Switzerland. This article is an open access article distributed under the terms and conditions of the Creative Commons Attribution (CC BY) license (http://creativecommons.org/licenses/by/4.0/).
Share and Cite
Agarbati, A.; Canonico, L.; Comitini, F.; Ciani, M. Reduction of Sulfur Compounds through Genetic Improvement of Native Saccharomyces cerevisiae Useful for Organic and Sulfite-Free Wine. Foods 2020, 9, 658. https://doi.org/10.3390/foods9050658
Agarbati A, Canonico L, Comitini F, Ciani M. Reduction of Sulfur Compounds through Genetic Improvement of Native Saccharomyces cerevisiae Useful for Organic and Sulfite-Free Wine. Foods. 2020; 9(5):658. https://doi.org/10.3390/foods9050658
Chicago/Turabian StyleAgarbati, Alice, Laura Canonico, Francesca Comitini, and Maurizio Ciani. 2020. "Reduction of Sulfur Compounds through Genetic Improvement of Native Saccharomyces cerevisiae Useful for Organic and Sulfite-Free Wine" Foods 9, no. 5: 658. https://doi.org/10.3390/foods9050658
APA StyleAgarbati, A., Canonico, L., Comitini, F., & Ciani, M. (2020). Reduction of Sulfur Compounds through Genetic Improvement of Native Saccharomyces cerevisiae Useful for Organic and Sulfite-Free Wine. Foods, 9(5), 658. https://doi.org/10.3390/foods9050658

